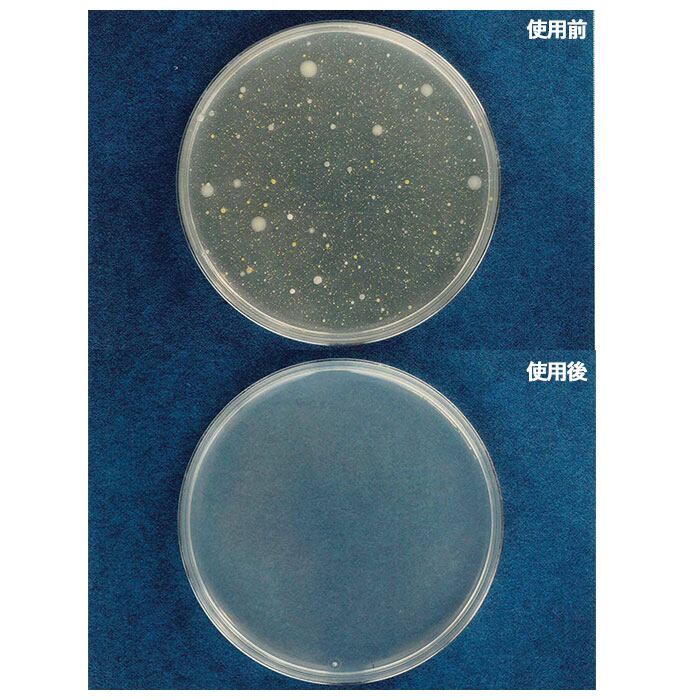

加湿器 除菌剤 通販 加湿器タンク タンク カビ対策 アロマの香り 加湿器用除菌 殺菌 洗浄剤 除菌水 除菌液 日本製 ユーカリ ラベンダー オレンジ コジット 日用品 雑貨 加湿器タンクの除菌剤 300ml
¥2,329 税込
SOLD OUT
この商品は送料無料です。
【宅配便】12時までの注文で最短翌日お届け
【ブランド名】
COGIT(コジット)
【商品名】
加湿器タンクの除菌剤 300ml
【商品説明】
・加湿器タンク内の水を除菌・カビ対策をしてくれる除菌剤300mlが登場。
・500ml以下のタンクにはキャップ1杯・1Lのタンクにはキャップ2杯の除菌剤を入れるだけ!(給水タンクを直接加熱するタイプにはご使用できません)
・天然由来成分が配合されているので、安心して使えるのがうれしい。
・無香料・ほのかなユーカリ・ほのかなラベンダー・ほのかなオレンジと4種類から香りが選べるので気分によって使い分けができる。
・300mlと大容量なので、何度も使えて経済的。
・安心の日本製。
【生産国】
日本
【サイズ】
※内容量は「容量欄」をご確認ください。
【重量】
約340g
【成分】
【無香料】アザディラクーン(ニームオイル)、大豆エキス、穀物エキス、界面活性剤、水
【ユーカリ】ユーカリエキス、アザディラクーン(ニームオイル)、大豆エキス、穀物エキス、界面活性剤、水
【ラベンダー】ラベンダーエキス、アザディラクーン(ニームオイル)、大豆エキス、穀物エキス、界面活性剤、水
【オレンジ】オレンジエキス、アザディラクーン(ニームオイル)、大豆エキス、穀物エキス、界面活性剤、水
【容量】
[内容量]300ml
【使用方法】
加湿器タンクに水を入れる際、本品を適量注いでご使用ください。
※本品をご使用になる前に、加湿器タンク及びトレイをよく洗浄してください。
【注意点】
※本品は加湿器タンク内の水を除菌するもので、空気を除菌するものではありません。
※全ての菌を除菌するものではありません。
※本品は油分を含んでいるため、一部の加湿器には使用できない場合があります。ご使用前に加湿器の取扱い説明書をご確認くたさい。
※万一飲み込んだ場合は水を十分飲み、医師の診断を受けてください。
※加湿器タンク内部に汚れが発生した場合は、加湿器メーカー指定の洗剤・クリーナーなどで洗浄してください。
※万一目に入った場合は流水で十分に洗浄し、医師の診断を受けてください。
※お子さまの手の届かないところに保管してください。
※誤用を避け品質を保持するために、他の容器に入れ替えないでください。
※本来の用途以外には使用しないでください。
※カメラやモニターの性質により、画像と実物の色の違いがある場合がございますのでご理解願います。
[使用量の目安]
※タンクサイズ500ml以下:5ml(キャップ1杯)以下
※タンクサイズ1リットル:10mL(キャップ2杯)
[使用可能な加湿器タイプ]
※スチームファン式、気化式、超音波式、その他水道水をタンクに注いで使用する加湿器にご使用いただます。
※給水タンクを直接加熱するタイプにはご使用できません。
このショップでは酒類を取り扱っています。20歳未満の者の飲酒は法律で禁止されています。
-
レビュー
(789)
-
送料・配送方法について
-
お支払い方法について
¥2,329 税込
SOLD OUT